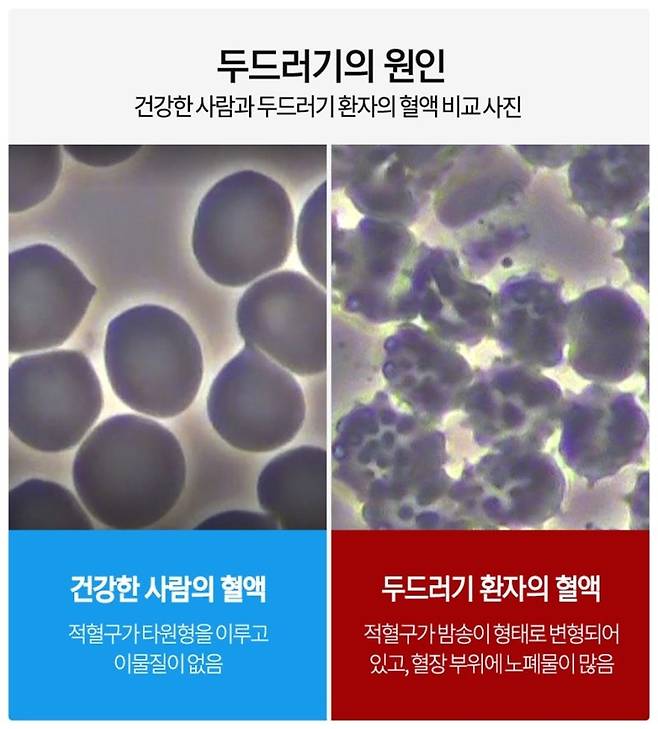

안녕하세요, 미독정입니다. 오늘은 많은 분들이 겪는 피부 고민, 특히 군포두드러기에 대해 자세히 알아보겠습니다. 피부는 단순히 외부 자극을 막는 역할뿐만 아니라, 우리 몸 내부의 건강 상태를 반영하는 거울과 같습니다. 따라서 피부에 이상이 생겼다면, 몸에 다른 문제가 있는 것은 아닌지 꼼꼼히 확인해야 합니다.

두드러기, 왜 생기는 걸까요?

두드러기는 남녀노소 누구에게나 발생할 수 있는 흔한 질환이지만, 원인과 증상은 매우 다양합니다. 특히 군포두드러기는 짧은 시간 안에 나타났다가 사라지는 특징 때문에 정확한 진단이 어려울 수 있습니다. 지금부터 군포두드러기의 종류와 원인, 그리고 효과적인 관리 방법에 대해 자세히 살펴보겠습니다.

1. 알레르기성 두드러기

가장 흔하게 알려진 두드러기 중 하나는 특정 음식에 대한 알레르기 반응으로 인해 발생하는 것입니다.

• 주의 사항: 알레르기는 개인마다 다르게 나타나며, 과거에 없던 알레르기가 갑자기 생길 수도 있습니다. 따라서 이상 증세가 나타나면 알레르기 검사를 통해 정확히 진단받는 것이 중요합니다.
• 증상: 피부 팽진뿐만 아니라 기도 확장으로 인한 질식까지 유발할 수 있으므로 주의해야 합니다.

2. 한랭 두드러기

급격한 온도 변화, 특히 찬 공기에 노출되었을 때 나타나는 두드러기입니다.

• 증상: 극심한 가려움증이 주된 증상이며, 환부를 긁을수록 증상이 악화됩니다.
• 예방: 기온이 낮은 날 교외 운동 시 보온에 유의하고, 찬 음식 섭취나 찬물 목욕은 피하는 것이 좋습니다.

3. 콜린성 두드러기

한랭 두드러기와는 반대로, 피부 온도가 급격하게 상승하면서 발생하는 두드러기입니다.

• 증상: 가려움증보다는 따가움이 심하며, 두통, 복통, 오한 등이 동반될 수 있습니다.
• 예방: 땀이 날 정도의 과한 활동, 뜨겁거나 매운 음식 섭취, 뜨거운 물 목욕 등을 피하는 것이 좋습니다.

군포두드러기, 어떻게 관리해야 할까요?

군포두드러기는 발생 후 짧은 시간 안에 사라지기 때문에 원인을 정확히 파악하기 어렵습니다. 따라서 전문가의 도움을 받아 정확한 진단을 받고, 적절한 조치를 취하는 것이 중요합니다.

1. 면역력 개선

식습관은 피부 질환의 발생과 악화에 큰 영향을 미칩니다. 장은 우리 몸에서 면역 세포를 가장 많이 보유하고 있는 기관이므로, 장 기능이 저하되면 면역 세포 활동량이 감소하여 피부 질환 발생 위험이 높아집니다.

• 유산균: 시중에서 판매하는 일반 유산균보다 4중 코팅된 유산균을 섭취하는 것이 좋습니다. 일반 유산균은 위산과 담즙산에 의해 사멸하기 쉬우므로, 코팅된 유산균이 장까지 살아서 도달하는 데 도움이 됩니다. 또한, 유산균의 먹이가 되는 프락토올리고당이 첨가된 유산균을 섭취하면 장내 증식에 더욱 효과적입니다.

2. 한약 치료

개인의 증상과 체질에 맞는 한약 처방은 군포두드러기 치료에 효과적일 수 있습니다. 하늘마음한의원에서는 동의보감 속 진료 방식을 토대로 개발된 가루 형태의 한약을 처방합니다. 탕약에 비해 약재 잔여물이 남지 않아 유효 성분 소실이 적다는 장점이 있습니다. 한약 복용은 장 기능 저하로 인해 발생한 체내 문제를 해결하는 데 도움을 줄 수 있습니다.

3. 체온 정상화 치료

군포두드러기 환자분들 중에는 일반인에 비해 체온이 낮거나, 상체는 뜨겁고 하체는 차가운 상열하한 체질을 가진 경우가 많습니다. 이러한 경우 혈류량이 감소하고 면역 세포 활동량이 줄어들어 면역력이 저하될 수 있습니다. 따라서 심부에 열을 가하는 치료를 통해 체온을 정상화하고, 면역력 향상과 더불어 한약 흡수율 및 유산균 증식을 도울 수 있습니다.

치료 후 관리도 중요합니다

군포두드러기 치료 후에는 재발 방지를 위한 꾸준한 관리가 필수적입니다. 피부 질환은 최소 1년 이상 재발하지 않아야 안심할 수 있습니다. 하늘마음한의원 안양범계점에서는 치료 종료 후에도 재발 관리를 통해 건강한 피부를 유지할 수 있도록 돕고 있습니다.

하늘마음한의원 안양범계
경기도 안양시 동안구 동안로 120 평촌올림픽 스포츠센터 7층

[미독정]